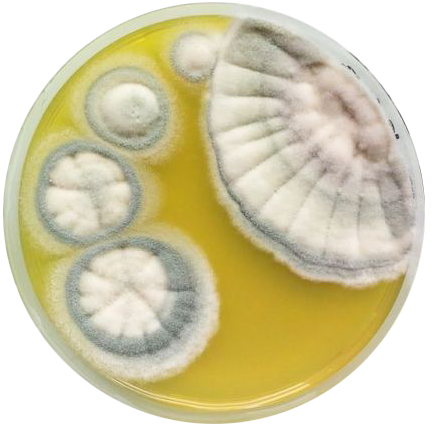

OGGI GIURO CHE NON MANGIO NULLA SE NON MONT BLANC
Great Martina, 2024
Medium: Video Loop of 14 Analog Photographs
Duration: 60 seconds
A video work composed of 14 analog shots, presumably taken during the spring months of 2023. The exact location where they were taken is now unknown due to the absence of defined visual indications and the fact that the photographs were developed months after their creation.
The idea for this project arose in response to a period of struggling with eating disorders, which persisted for more than two years during adolescence. This experience proved to be profoundly influential for the artist; the obsessive control over food gradually led to a loss of interest in external events and a consequent difficulty in remembering certain moments. It also represented a limitation in fully experiencing various events. Thus, the loop fluxes of photographs mirror the illness that permeated those moments. Almost as if they were enveloped in a cream-coloured patina, they symbolize the transformation and distortion of memories on one hand, and on the other, they embody the eating disorder itself, which, as experienced by the artist, has consumed memories, moments, and years.
Great Martina, 2024
Medium: Video Loop of 14 Analog Photographs
Duration: 60 seconds
A video work composed of 14 analog shots, presumably taken during the spring months of 2023. The exact location where they were taken is now unknown due to the absence of defined visual indications and the fact that the photographs were developed months after their creation.
The idea for this project arose in response to a period of struggling with eating disorders, which persisted for more than two years during adolescence. This experience proved to be profoundly influential for the artist; the obsessive control over food gradually led to a loss of interest in external events and a consequent difficulty in remembering certain moments. It also represented a limitation in fully experiencing various events. Thus, the loop fluxes of photographs mirror the illness that permeated those moments. Almost as if they were enveloped in a cream-coloured patina, they symbolize the transformation and distortion of memories on one hand, and on the other, they embody the eating disorder itself, which, as experienced by the artist, has consumed memories, moments, and years.

SANA
Inkar Seitkulova, 2024
Medium: Installation
Size: 60 x 46 x 145 cm
This installation bridges ancient nomadic traditions with contemporary reflection. The Kese, a traditional Kazakh teacup made from air-dry clay, is mounted upside down on a white stand above the Korpe, a traditional seating mat.
The Kese features abstract ornaments of interconnected circles resembling embryos, symbolizing birth and life's cyclical nature. Inside, engraved mold patterns honor life once lived, contrasting with today's sanitized version of nature. Traditionally, the Kese is never dried upside down to prevent mold, symbolizing the enduring connection between Sky (Tengri) and Land (Umai).
"Sana" ("consciousness" in Kazakh) invites contemplation on cultural identity and humanity's evolving relationship with the environment.
Inkar Seitkulova, 2024
Medium: Installation
Size: 60 x 46 x 145 cm
This installation bridges ancient nomadic traditions with contemporary reflection. The Kese, a traditional Kazakh teacup made from air-dry clay, is mounted upside down on a white stand above the Korpe, a traditional seating mat.
The Kese features abstract ornaments of interconnected circles resembling embryos, symbolizing birth and life's cyclical nature. Inside, engraved mold patterns honor life once lived, contrasting with today's sanitized version of nature. Traditionally, the Kese is never dried upside down to prevent mold, symbolizing the enduring connection between Sky (Tengri) and Land (Umai).
"Sana" ("consciousness" in Kazakh) invites contemplation on cultural identity and humanity's evolving relationship with the environment.






try again
try again
try again
try again

22
Chuhan Xiang, 2024
Medium: Installation
Size : 65×65×75
The photographic image acts as a signifying surface. In most cases, it indexes an external object in the spatiotemporal domain, its abstract intention being to render that object comprehensible. The artwork comprises the totality of images Xiang captured between February 9th, 2022 and February 9th, 2023, memorialising her 22nd year of life. Each photograph has been individually transformed into an extreme cross-section of its momentary subject, their accumulation cohering into a novel visual form. Throughout her brief existence, an exaggerated reverence for the photographic image has made me cognizant that the vital elements lie beyond the image. It is an experience unconstrained by time or space - a confluence of memory, site-specificity, and diverse affect. The recording of myriad phenomena is an aleatory, unconscious act, yet the resulting photographs are an inevitable consequence of this behaviour. This piece serves as an expression of gratitude to the artist’s mother for the birthday cake her mother made for her 22nd birthday and for everything she has done for the artist.
Chuhan Xiang, 2024
Medium: Installation
Size : 65×65×75
The photographic image acts as a signifying surface. In most cases, it indexes an external object in the spatiotemporal domain, its abstract intention being to render that object comprehensible. The artwork comprises the totality of images Xiang captured between February 9th, 2022 and February 9th, 2023, memorialising her 22nd year of life. Each photograph has been individually transformed into an extreme cross-section of its momentary subject, their accumulation cohering into a novel visual form. Throughout her brief existence, an exaggerated reverence for the photographic image has made me cognizant that the vital elements lie beyond the image. It is an experience unconstrained by time or space - a confluence of memory, site-specificity, and diverse affect. The recording of myriad phenomena is an aleatory, unconscious act, yet the resulting photographs are an inevitable consequence of this behaviour. This piece serves as an expression of gratitude to the artist’s mother for the birthday cake her mother made for her 22nd birthday and for everything she has done for the artist.






PULSE PIECE
Boyang Xie, 2024
Medium: Installation
Duration: 29.7 x 42 cm
The artwork inspired by Yoko Ono's poetry, PULSE PIECE constructs an installation using everyday food items. Avocados and eggs look similar and have completely different destinies. If they could talk with each other, how would they communicate and what would they say? This work is the artist's reflection on the origin of life and the world.
Boyang Xie, 2024
Medium: Installation
Duration: 29.7 x 42 cm
The artwork inspired by Yoko Ono's poetry, PULSE PIECE constructs an installation using everyday food items. Avocados and eggs look similar and have completely different destinies. If they could talk with each other, how would they communicate and what would they say? This work is the artist's reflection on the origin of life and the world.


DON'T PLAY WITH FOOD
Kasina Arunchaipong, 2024
Medium: Video
Duration: 8 minutes 19 seconds, loop
It starts with the yearning to reminisce back to the sentiment you had as a kid, interacting with the world for the first time. When shape, texture and color entices you to compose your own sensibility of what’s around us. Our tools, our toys to play with the world. Our creativity that later get mores constrained as we grow older, ‘Don’t play with food’, the repeated phrase that told us to be proper, distancing yourself away from that spontaneity. Be an adult.
Arunchaipong’s proposal is to simply go back to that sense of ‘playing’. And there she thinks of piano, one of the things that she plays and gives her so much joy, but with a so-called ‘responsibility of an adult’ that she unknowingly deprives herself of that joyfulness that she once enjoyed. That stream of unconscious flow that lies dormant, awaits to be tapped into again when we can remind ourselves of what ‘blocks’ us from it. Reaching back to her nostalgia.
And here she is, playing her favorite piano piece ‘Arabesque n.1’ by Debussy on an expired yogurt.
Kasina Arunchaipong, 2024
Medium: Video
Duration: 8 minutes 19 seconds, loop
It starts with the yearning to reminisce back to the sentiment you had as a kid, interacting with the world for the first time. When shape, texture and color entices you to compose your own sensibility of what’s around us. Our tools, our toys to play with the world. Our creativity that later get mores constrained as we grow older, ‘Don’t play with food’, the repeated phrase that told us to be proper, distancing yourself away from that spontaneity. Be an adult.
Arunchaipong’s proposal is to simply go back to that sense of ‘playing’. And there she thinks of piano, one of the things that she plays and gives her so much joy, but with a so-called ‘responsibility of an adult’ that she unknowingly deprives herself of that joyfulness that she once enjoyed. That stream of unconscious flow that lies dormant, awaits to be tapped into again when we can remind ourselves of what ‘blocks’ us from it. Reaching back to her nostalgia.
And here she is, playing her favorite piano piece ‘Arabesque n.1’ by Debussy on an expired yogurt.
FALTA
DE
mão

tão
horrívei
maS
tão
perfeitas
elA
ficou
de
água
MOTHER TONGUE
Mariana Paku, 2024
Medium: Watercolor drawings on cotton paper, starter, recipe
Size: 81 x70 cm
The artwork consists of one large drawing, a rushed look might capture abstractions, but a closer and more attentive approach starts to broaden the lines into creature-like things and small ecosystems; it's hard to tell if these are living things or they are far beyond dead. For the artist, they might even be decomposing beings – leftovers from a different time. Alongside it – on its altar – there is a folded piece of paper (the recipe the artist cooked with her mother) and the once-living starter on top.
Mariana Paku, 2024
Medium: Watercolor drawings on cotton paper, starter, recipe
Size: 81 x70 cm
The artwork consists of one large drawing, a rushed look might capture abstractions, but a closer and more attentive approach starts to broaden the lines into creature-like things and small ecosystems; it's hard to tell if these are living things or they are far beyond dead. For the artist, they might even be decomposing beings – leftovers from a different time. Alongside it – on its altar – there is a folded piece of paper (the recipe the artist cooked with her mother) and the once-living starter on top.




THE NURTURER
Daniela Del Pozo, 2024
Medium: Acrylic on canvas
Size: 35 x 50 cm
An acrylic on canvas painting. In the painting, the artist speaks of how Colombia is a country of big contradictions, where dance and laughter coexist with violence, everyday difficulties, and harsh living conditions and where parallel socioeconomic realities clash.
One of the strongest contradictions evidenced itself in different topics surrounding women and their bodies: while women and their bodies are largely celebrated there are also strict parameters that dictate social conventions related to their beauty and attractiveness. Women grow up within this frame, enclosing different aspects of their lives to fit the standard, developing conflictive relationships with food and with their own bodies, amongst others. As a result, body dysmorphia and eating disorders affect thousands, if not millions, of women in the country.
In this sense, the painting points towards the very needed healing between a woman and their eating habits and between a woman and their untamed, natural body (with its natural proportions and fat). All of this is in a playful context of the Colombian Caribbean Coast.
Daniela Del Pozo, 2024
Medium: Acrylic on canvas
Size: 35 x 50 cm
An acrylic on canvas painting. In the painting, the artist speaks of how Colombia is a country of big contradictions, where dance and laughter coexist with violence, everyday difficulties, and harsh living conditions and where parallel socioeconomic realities clash.
One of the strongest contradictions evidenced itself in different topics surrounding women and their bodies: while women and their bodies are largely celebrated there are also strict parameters that dictate social conventions related to their beauty and attractiveness. Women grow up within this frame, enclosing different aspects of their lives to fit the standard, developing conflictive relationships with food and with their own bodies, amongst others. As a result, body dysmorphia and eating disorders affect thousands, if not millions, of women in the country.
In this sense, the painting points towards the very needed healing between a woman and their eating habits and between a woman and their untamed, natural body (with its natural proportions and fat). All of this is in a playful context of the Colombian Caribbean Coast.










THE DAILY ORANGE
Luisa Flores, 2024
Medium: Orange printed with paint on cotton paper
Size: 59.4 x 84.1 cm
The artwork stems from the artist’s breakfast morning routine. Having an orange has become sort of a ritual for Luisa. It gives the artist comfort and feels like the vitamins will protect her from getting sick. Luisa drew inspiration from the simplicity of this act yet also its repetitiveness. She knew she wanted to use the orange itself to create something she wanted to tell a story through it. After experimenting with using its juice to create shapes she decided to print the orange over on canvas with paint. Seeing how the orange was stamped over and over felt very honest. It captured the ritual that she believes most humans have and also symbolised the relationship the artist holds with food. Whether a food is healthy or not is a compulsive thought also repeated on her day to day. It’s something she really has been struggling with. It’s silent as only she will understand it’s there so sharing it also was very healing for her. It’s a visual representation of how she approaches food and how it makes the artist feel.
Luisa Flores, 2024
Medium: Orange printed with paint on cotton paper
Size: 59.4 x 84.1 cm
The artwork stems from the artist’s breakfast morning routine. Having an orange has become sort of a ritual for Luisa. It gives the artist comfort and feels like the vitamins will protect her from getting sick. Luisa drew inspiration from the simplicity of this act yet also its repetitiveness. She knew she wanted to use the orange itself to create something she wanted to tell a story through it. After experimenting with using its juice to create shapes she decided to print the orange over on canvas with paint. Seeing how the orange was stamped over and over felt very honest. It captured the ritual that she believes most humans have and also symbolised the relationship the artist holds with food. Whether a food is healthy or not is a compulsive thought also repeated on her day to day. It’s something she really has been struggling with. It’s silent as only she will understand it’s there so sharing it also was very healing for her. It’s a visual representation of how she approaches food and how it makes the artist feel.








































MUKEKA; MEMÓRIAS, DENDÊ E CAMARÃO
Vitória Brinker, 2024
Medium: Video
Duration: 25 minutes and 47 seconds
A video performance in which two artists eat and cook together. The artist is the host Vitória Brinker and the guest; is a Portuguese artist Inês Belmonte. The artwork uses the preparation of “Moqueca”, this traditional Bahian dish, to explore the colonial legacy, experiences of diaspora and migration, through the gesture of cooking and sharing this meal. By reversing the historical dynamic where enslaved women cooked for their masters, the performance reclaims power and agency, transforming the kitchen into a space of empowerment and cultural connection. Through this encounter, the piece questions how food can be a multiple acts, of memory, resistance and love, how it shapes cultural identities and how shared kitchens can be part of the way for healing colonial scars.
Vitória Brinker, 2024
Medium: Video
Duration: 25 minutes and 47 seconds
A video performance in which two artists eat and cook together. The artist is the host Vitória Brinker and the guest; is a Portuguese artist Inês Belmonte. The artwork uses the preparation of “Moqueca”, this traditional Bahian dish, to explore the colonial legacy, experiences of diaspora and migration, through the gesture of cooking and sharing this meal. By reversing the historical dynamic where enslaved women cooked for their masters, the performance reclaims power and agency, transforming the kitchen into a space of empowerment and cultural connection. Through this encounter, the piece questions how food can be a multiple acts, of memory, resistance and love, how it shapes cultural identities and how shared kitchens can be part of the way for healing colonial scars.





THE SPAGHETTI FRENZY
Chitrali Goswami, 2024
Medium: Video
Duration: 3 minutes and 45 seconds
The artwork is based on the movie La Grande Bouffatte. It's a video which shows cooking Italian dishes like pasta in which the artist also records herself eating it violently through which she depicts the extravagance and overeating which is shown in the movie. Violence is the key in her video.
Chitrali Goswami, 2024
Medium: Video
Duration: 3 minutes and 45 seconds
The artwork is based on the movie La Grande Bouffatte. It's a video which shows cooking Italian dishes like pasta in which the artist also records herself eating it violently through which she depicts the extravagance and overeating which is shown in the movie. Violence is the key in her video.



if(LOVE &= INTERCONNECTION)
Yue Zhao & Xue Chen, 2024
Medium: Performance
Duration: 18 minutes 32 seconds
A performance art by two artists, incorporating elements such as a Playtronica MIDI circuit board, everyday cooking ingredients, a kitchen knife, seasonings, a potable oven with a pot, and a laptop computer running sound software. The artists' bodies are connected to conductive food items using the Playtronica device, forming a closed-loop circuit. When the artists chop the ingredients, it affects the circuit's resistance; this data is converted by the Playtronica board into MIDI signals, which are fed into the computer. These signals are used to generate irregular musical notes. Finally, the chopped ingredients are cooked in the pot, after which the audience can choose seasonings and consume the prepared food.
Yue Zhao & Xue Chen, 2024
Medium: Performance
Duration: 18 minutes 32 seconds
A performance art by two artists, incorporating elements such as a Playtronica MIDI circuit board, everyday cooking ingredients, a kitchen knife, seasonings, a potable oven with a pot, and a laptop computer running sound software. The artists' bodies are connected to conductive food items using the Playtronica device, forming a closed-loop circuit. When the artists chop the ingredients, it affects the circuit's resistance; this data is converted by the Playtronica board into MIDI signals, which are fed into the computer. These signals are used to generate irregular musical notes. Finally, the chopped ingredients are cooked in the pot, after which the audience can choose seasonings and consume the prepared food.















IS MY LIFE FALLING APART OR DO I JUST NEED A SNACK?
Natalia Bustamante McEwen, 2024
Medium: Fanzine
Size: 29.7 x 42 cm
Natalia Bustamante McEwen, 2024
Medium: Fanzine
Size: 29.7 x 42 cm










